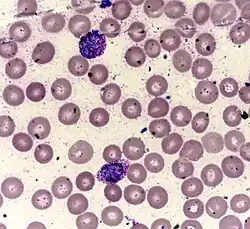

Coloração de Leishman
Coloração de Leishman (CAS:12627-53-1, EC: 235-732-1, MFCD:00131498), também corante de Leishman, é usado em microscopia para colorir esfregaços de sangue. Ele fornece excelente qualidade de coloração. Geralmente é usado para diferenciar e identificar leucócitos, parasitas da malária e tripanossomas. É baseada em uma mistura metanólica de azul de metileno “policromado” (i.e. demetilado em vários corantes azures) e eosina. A solução estoque metanólica é estável e também serve ao propósito de fixar diretamente o esfregaço eliminando um passo de pré-fixação. Se uma solução de trabalho é feita por diluição com um tampão aquoso a mistura resultante é muito instável e não pode ser usada por muito tempo. A coloração de Leishman é nomeada devido a seu inventor, o patologista escocês William Boog Leishman. É similar e parcialmente substituível pelas colorações de Giemsa, Jenner e Wright (Ver mais detalhes na seção Vantagens e desvantagens e comparações abaixo). Como eles, é uma versão da coloração de Romanowsky.
Preparação de fonte comercial
Muitas empresas vendem corante de Leishmann de boa qualidade na forma de um pó seco. As precauções a seguir devem ser tomadas durante a preparação.[1]
- Todo instrumental de vidro usado (como o cilindro graduado, o funil e o frasco de estocagem de vidro âmbar) deve ser seco completamente livre de água antes do uso.
- Tanto o frasco de metanol como a recentemente preparada solução de corante devem ser apropriadamente rotuladas e precauções como Substâncias Inflamáveis e Tóxicas' (Metanol se ingerido pode causar cegueira e também é perigoso se entra em contato diretamente com os olhos, então, preferencialmente, escudos faciais, luvas, filtro respiratório tipo N95 (EUA) ou tipo P1 (EN143), são fortemente recomendados quando um grande volume de metanol está sendo usado, como durante a preparação de reagentes em significativas quantidades.)
Sob as precauções acima, o pó deve ser bem misturado no metanol anidro de boa qualidade numa proporção de 0,6g de pó em 400 ml de metanol. Utilizar peças (como esferas) de vidro para agitação ou um agitador magnético ou cuidadosamente aquecer a aproximadamente 37°C pode ajudar na dissolução.
'Uma alíquota do corante (e.g. normalmente 50-100 ml) deve ser filtrada para uma unidade de distribuição para utilização diária e as seguintes condições de armazenamento devem ser seguidas.'
Estocagem
A luz brilhante e o calor oxidam o corante, especialmente quando em solução aquosa e causam precipitação de precipitados insolúveis, e.g. de violeta de metileno (Bernthsen). Evaporação de metanol, absorção de umidade e precipitação de sais Azure-Eosinato são também problemas adicionais durante a estocagem que requer a filtração da solução estoque quando da tomada de alíquotas para uso diário.[2]
Para uso diário, armazena-se o corante de forma hermética (prevenindo a umidificação do corante), em frasco âmbar (semi-opaco). Um frasco com tampa com conta-gotas, e.g. o frasco conta-gotas TK pode ser usado, o qual deve ser mantido bem fechado quando não estiver em uso. Manter em lugar fresco (não refrigerado) e nunca em luz solar direta.
A solução estoque de corante deve ser mantida num recipiente escuro (e.g., vidro âmbar) com uma tampa bem fechada num local escuro e fresco. Renovar a cada 3 meses ou mais cedo se indicado. Para obter uma reação de cor ótima, alguns sugerem que 3-5 dias devem ser permitidos antes de usar a solução corante recentemente preparada.
Métodos de coloração
Existem várias maneiras de fazer esta coloração. Um método comumente usado é:[3]
1 Tome um esfregaço de sangue seco ao ar em uma lâmina de vidro e cubra o esfregaço com o corante não diluído. Tome cuidado para não transbordar com excesso de corante. De preferência, adicione apenas o número suficiente de gotas para cobrir o esfregaço. Para padronizar, a contagem do número de gotas (usualmente 7-10) requerido para cobrir a película (de modo que possa ser adicionado o dobro do número de água) e ajustar o tempo de incubação de acordo com o resultado (usualmente 1–2 minutos, 3 minutos para WHO). A coloração não diluída age tanto como um fixador como também colore parcialmente o esfregaço. Ainda assim, uma vez que o teor de umidade pode variar é melhor fixar a lâmina em metanol antes da coloração.
2 Adicione duas vezes o volume água tamponada pH 6,8 (i.e. se e.g. 7 gotas de corante foram usadas, então use 14 gotas de água) para diluir o corante, comando cuidado que o corante não deve transbordar (o que tornará a diluição imprecisa). No entanto, o procedimento operacional padrão publicado pela WHO (Organização Mundial de Saúde) sugere a adição igual de volume de água (em vez de duas vezes).[4] Misture a água com a coloração embaixo suavemente soprando com um tubo, como um canudo plástico, ou usando uma pipeta de bulbo de plástico. Permita corar por 10–12 minutes (tempo este que pode requerer ajustes). Neste método, é necessária uma melhor ionização durante a diluição pelo tampão aquoso neste passo para completar a coloração. O protocolo da OMS também esclarece que durante esta incubação
- "o aparecimento de uma 'escória' policromática sobre a superfície da lâmina é meramente um resultado de oxidação dos componentes do corante e pode ser ignorado."
3. Lave o corante com água da torneira límpida (ou filtrada). Se o corante é derramado ao invés de ser lavado, isto irá deixar um fino depósito cobrindo a película. Limpe a parte traseira da lâmina limpa e coloque-a em uma prateleira de drenagem para secar. O esfregaço colorido deve aparecer grosseira nem demasiadamente cor-de-rosa nem demasiado azul (verifica-se resultados microscópicos finais). Se a água da torneira for altamente ácida, resultará em esfregaço grosseiramente rosa muito rápido, ou, se altamente alcalina, resultando em esfregaço que permanece muito azul, pode-se tentar usar água fervida fervida ou água de chuva filtrada ou água tamponada a pH 6,8 a qual pode ser usada como um passo de lavagem adicional após lavagem em água corrente.
4. A lâmina deve ser seca ao ar e pode ser observada sob microscópio tanto direta como operacionalmente (para WHO) um meio de montagem não aquoso sintético tal como DPX (Distrene 80 - um poliestireno comercial, a Plasticizer (plastificante) e.g. dibutyl phthalate (dibutilftalato) e Xylene (xileno)) pode ser usado.
Vantagens, desvantagens e comparações
Vantagens
Facilidade de técnica
De acordo com o livro texto de Sir John Vivian Dacie de hematologia prática, Practical Haematology:[5]
- "Entre as colorações de Romanowsky agora em uso, a coloração de Jenner é a mais simples e a de Giemsa a mais complexa. Coloração de Leishman, a qual ocupa uma posição intermediária, ainda é amplamente utilizada na rotina de coloração."
O protocolo WHO (World Health Organization, Organização Mundial da Saúde) menciona:[4]
- "Existem várias combinações diferentes destes corantes que variam em suas características de coloração. May-Grunwald-Giemsa é um bom método para trabalho de rotina. A coloração de Wrigh é um método mais simples, enquanto o [método] de Leishman é também um método simples que é especialmente adequado quando uma película de sangue manchada é necessária urgentemente ou a coloração de rotina não está disponível (e.g. a noite). A coloração de Field é uma coloração rápida usada primariamente sobre películas finas para parasitas da malária. Seja qual for o método utilizado, é importante selecionar corantes que não sejam contaminado com outros corantes ou sais metálicos."
Sir William Boog Leishman de Londres e Karl Reuter da Alemanha independentemente descobriram em 1901 o que é considerado "Talvez as mais práticas modificações da coloração de Malachowski"[6] Eles adotaram os melhores aspectos das colorações desenvolvidas por Malachowski e Jenner, i.e., eles usaram tanto azul de metileno policromado (acidentalmente feito por Romanowsky que obteve o nome, sistematicamente feito por Ernst Malachowski mesmo antes por Romanowsky, e redescoberto por Bernhard Nocht, mas desconhecido por Jenner, May, Grunwald e muitos outros usaram simples azul de metileno) e filtrando o precipitado de eosinato de azure da mistura aquosa e dissolvendo em solvente alcoólico (a percepção de Jenner sobre o método). Diferenças entre os métodos de Leishman e de Reuter são: Leishman usou metanol (como Jenner) e substituiu Eosina B por Eosina Y, enquanto usou álcool etílico e salientou, com razão, a importância do uso de um solvente absolutamente puro. Ambos os métodos produziram uma coloração estável e a cor púrpura desejada.
Referências
- ↑ District Laboratory Practice in Tropical Countries, Part 2 By Monica Cheesbrough, Appendix I, Preparation of Reagents and Culture Media, p396
- ↑ District Laboratory Practice in Tropical Countries, Part 2 By Monica Cheesbrough, Section 8 Hematological Tests, subsection 8.7 Blood Films, p322
- ↑ District Laboratory Practice in Tropical Countries, Part 2 By Monica Cheesbrough, Section 8 Hematological Tests, subsection 8.7 Blood Films
- ↑ a b «Blood Safety and Clinical Technology Guidelines on Standard Operating Procedures for HAEMATOLOGY Chapter 11 - Preparation and Staining of Blood Films, (Last update: 27 April 2006)». Consultado em 19 de maio de 2017. Arquivado do original em 1 de abril de 2012
- ↑ John Vivian Dacie, John Vivian Dacie (Sir.), Shirley Mitchell Lewis; Practical haematology; Churchill Livingstone, 1995.
- ↑ Biotech Histochem. 2011 Feb;86(1):7-35. The Color Purple: from Royalty to Laboratory, with Apologies to Malachowski. Krafts KP, Hempelmann E, Oleksyn BJ.